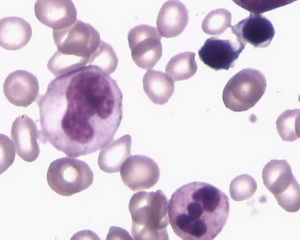
巨幼紅細胞性貧血 巨幼紅細胞性貧血

疾病簡介
巨幼細胞性貧血病因
1.葉酸缺乏的病因
(1)攝入不足葉酸每天的需要量為200~400µg。人體內葉酸的儲存量僅夠4個月之需。食物中缺少新鮮蔬菜、過度烹煮或醃製均可使葉酸丟失。乙醇可干擾葉酸的代謝,酗酒者常會有葉酸缺乏。小腸(特別是空腸段)炎症、腫瘤、手術切除及熱帶性口炎性腹瀉均可導致葉酸的吸收不足。
(2)需要增加妊娠期婦女每天葉酸的需要量為400~600µg。生長發育的兒童及青少年以及慢性反覆溶血、白血病、腫瘤、甲狀腺功能亢進及長期慢性腎功能衰竭用血液透析治療的患者,葉酸的需要都會增加,如補充不足就可發生葉酸缺乏。
(3)藥物的影響如甲氨蝶呤、氨苯蝶啶、乙胺嘧啶能抑制二氫葉酸還原酶的作用,影響四氫葉酸的生成。苯妥英鈉、苯巴比妥對葉酸的影響機制不明,可能是增加葉酸的分解或抑制DNA合成。約67%口服柳氮磺胺吡啶的患者葉酸在腸內的吸收受抑制。
(4)其他先天性缺乏5,10-甲醯基四氫葉酸還原酶的患者,常在10歲左右才被診斷。有些加強護理病房(ICU)的患者常可出現急性葉酸缺乏。
2.維生素B12缺乏的病因
(1)攝入減少人體內維生素B12的儲存量約為2~5mg,每天的需要量僅為0.5~1µg。正常時,每天有5~10µg的維生素B12隨膽汁進入腸腔,胃壁分泌的內因子可足夠地幫助重吸收膽汁中的維生素B12。故素食者一般約需10~15年才會發展為維生素B12缺乏。老年人和胃切除患者胃酸分泌減少,常會有維生素B12缺乏。由於有膽汁中的維生素B12的再吸收(腸肝循環),這類患者也和素食者一樣,需經過10~15年才出現維生素B12缺乏的臨床表現。故一般由於膳食中維生素B12攝入不足而致巨幼細胞貧血者較為少見。
(2)內因子缺乏主要見於萎縮性胃炎、全胃切除術後和惡性貧血患者。發生惡性貧血的機制目前還不清楚。患者常有特發的胃黏膜完全萎縮和內因子的抗體存在,故有人認為惡性貧血屬免疫性疾患。這類患者由於缺乏內因子,食物中維生素B12的吸收和膽汁中維生素B12的重吸收均有障礙。
(3)嚴重的胰腺外分泌不足這類患者容易導致維生素B12的吸收不良,這是因為在空腸內維生素B12-R蛋白複合體需經胰蛋白酶降解,維生素B12才能釋放出來,與內因子相結合。這類患者一般在3~5年後會出現維生素B12缺乏的臨床表現。由於慢性胰腺炎患者通常會及時補充胰蛋白酶,故在臨床上合併維生素B12缺乏的並不多見
(4)細菌和寄生蟲小腸記憶體在異常高濃度的細菌和寄生蟲也可影響維生素B12的吸收,因為這些有機物可大量攝取和截留維生素B12。小腸憩室或手術後的盲端襻中常會有細菌滋生以及腸內產生的魚絛蟲,都會與人體競爭維生素B12,從而引起維生素B12缺乏。
(5)先天性轉鈷蛋白Ⅱ(TCⅡ)缺乏及接觸氧化亞氮(麻醉劑)可影響維生素B12的血漿轉運和細胞內的利用,亦可造成維生素B12缺乏。
臨床表現
巨幼細胞性貧血(1)貧血貧血起病隱匿,特別是維生素B12缺乏者常需數月。而葉酸由於體內儲存量少,可較快出現缺乏。某些接觸氧化亞氮者、ICU病房或血液透析的患者,以及妊娠婦女可在短期內出現缺乏,臨床上一般表現為中度至重度貧血,除貧血的症狀如乏力、頭暈、活動後氣短心悸外,嚴重貧血者可有輕度黃疸,可同時有白細胞數和血小板減少,患者偶有感染及出血傾向
(2)胃腸道症狀胃腸道症狀表現為反覆發作的舌炎,舌面光滑、乳突及味覺消失、食欲不振。腹脹、腹瀉及便秘偶見。
(3)神經系統症狀維生素B12缺乏特別是惡性貧血的患者常有神經系統症狀,主要是由於脊髓後、側索和周圍神經受損所致。表現為乏力、手足對稱性麻木、感覺障礙、下肢步態不穩、行走困難。小兒及老年人常表現腦神經受損的精神異常、無欲、抑鬱、嗜睡或精神錯亂。部分巨幼細胞貧血患者的神經系統症狀可發生於貧血之前。
上述三組症狀在巨幼細胞貧血患者中可同時存在也可單獨發生,同時存在時其嚴重程度也可不一致。
2.特殊類型臨床表現
(1)麥膠腸病及乳糜瀉(非熱帶性口炎性腹瀉或特發性脂肪下痢)麥膠腸病在兒童患者中稱為乳糜瀉,常見於溫帶地區,發病與進食某些穀類物質中的麥膠有關,患者同時對多種營養物質,如脂肪、蛋白質、碳水化合物、維生素以及礦物質的吸收均有障礙。臨床表現為乏力、間斷腹瀉、體重減輕、消化不良、腹脹、舌炎和貧血。大便呈水樣或糊狀,量多、泡沫多、很臭、有多量脂肪。血象和骨髓象為典型的巨幼細胞貧血,血清和紅細胞葉酸水平降低。治療主要是對症及補充葉酸,可以取得較好的效果,貧血糾正後宜用小劑量葉酸維持治療,不進食含麥膠的食物亦很重要。
(2)熱帶口炎性腹瀉(熱帶營養性巨幼細胞貧血)本病病因不清楚。多見於印度、東南亞、中美洲以及中東等熱帶地區的居民和旅遊者。臨床症狀與麥膠腸病相似。血清葉酸及紅細胞葉酸水平降低、用葉酸治療加廣譜抗生素能使症狀緩解及貧血糾正。緩解後套用小劑量葉酸維持治療以防止復發。
(3)乳清酸尿症乳清酸尿症是一種遺傳性嘧啶代謝異常的疾病。除有巨幼細胞貧血外,尚有精神發育遲緩及尿中出現乳清酸結晶。患者的血清葉酸或維生素B12的濃度並不低,用葉酸或維生素B12治療無效,用尿嘧啶治療可糾正貧血。
(4)惡性貧血惡性貧血是由於胃黏膜萎縮、胃液中缺乏內因子,因而不能吸收維生素B12而發生的巨幼細胞貧血。發病機制尚不清楚,似與種族和遺傳有關。我國罕見。
檢查
1.血象大細胞正色素性貧血(MCV>100fl),血象往往呈現全血細胞減少。中性粒細胞及血小板計數均可減少,但比貧血的程度為輕。血塗片中可見多數大卵圓形的紅細胞,中性粒細胞分葉過多,可有5葉或6葉以上的分葉。偶可見到巨大血小板。網織紅細胞計數正常或輕度增高。
2.骨髓象
骨髓呈增生活躍,紅系細胞增生明顯,各系細胞均有巨幼變,以紅系細胞最為顯著。紅系各階段細胞均較正常大,胞質比胞核發育成熟(核質發育不平衡),核染色質呈分散的顆粒狀濃縮。類似的形態改變亦可見於粒細胞及巨核細胞系,以晚幼和桿狀核粒細胞更為明顯。
3.生化檢查
血清葉酸和/或維生素B12水平低於正常,但因為這兩類維生素的作用均在細胞內,而非血漿中,故可進一步測定紅細胞葉酸水平、血清高半胱氨酸和甲基丙二酸水平。
4.內因子抗體測定
在惡性貧血患者的血清中,內因子阻斷抗體(I型抗體)的檢出率在50%以上,故內因子阻斷抗體測定為惡性貧血的篩選方法之一。如陽性,應做維生素B12吸收試驗
5.維生素B12吸收試驗
主要用來判斷維生素B12缺乏的病因。
診斷
1.有葉酸、維生素B12缺乏的病因及臨床表現。2.外周血呈大細胞性貧血(MCV>100fl),中性粒細胞核分葉過多,5葉者>5%或有6葉者出現。
3.骨髓呈現典型的巨幼型改變,,無其他病態造血表現。
4.血清葉酸水平降低<6.81nmol/L、紅細胞葉酸水平<227nmol/L、維生素B12水平降低<75pmol/L。
5.試驗性治療有效。
治療
1.一般治療
治療基礎疾病,去除病因。加強營養知識教育糾正偏食及不良的烹調習慣。
2.補充葉酸或維生素B12
(1)葉酸缺乏口服葉酸。胃腸道不能吸收者可肌肉注射四氫葉酸鈣,直至血紅蛋白恢復正常。一般不需維持治療。
(2)維生素B12缺乏肌肉注射維生素B12,直至血紅蛋白恢復正常。惡性貧血或胃全部切除者需終生採用維持治療。維生素B12缺乏伴有神經症狀者對治療的反應不一,有時需大劑量、長時間(半年以上)的治療。對於單純維生素B12缺乏的患者,不宜單用葉酸治療否則會加重維生素B12的缺乏,特別是要警惕會有神經系統症狀的發生或加重。
(3)嚴重的巨幼細胞貧血患者在補充治療後要警惕低血鉀症的發生。因為在貧血恢復的過程中,大量血鉀進入新生成的細胞內,會突然出現低鉀血症,對老年患者和有心血管疾患、納差者應特別注意及時補充鉀鹽。